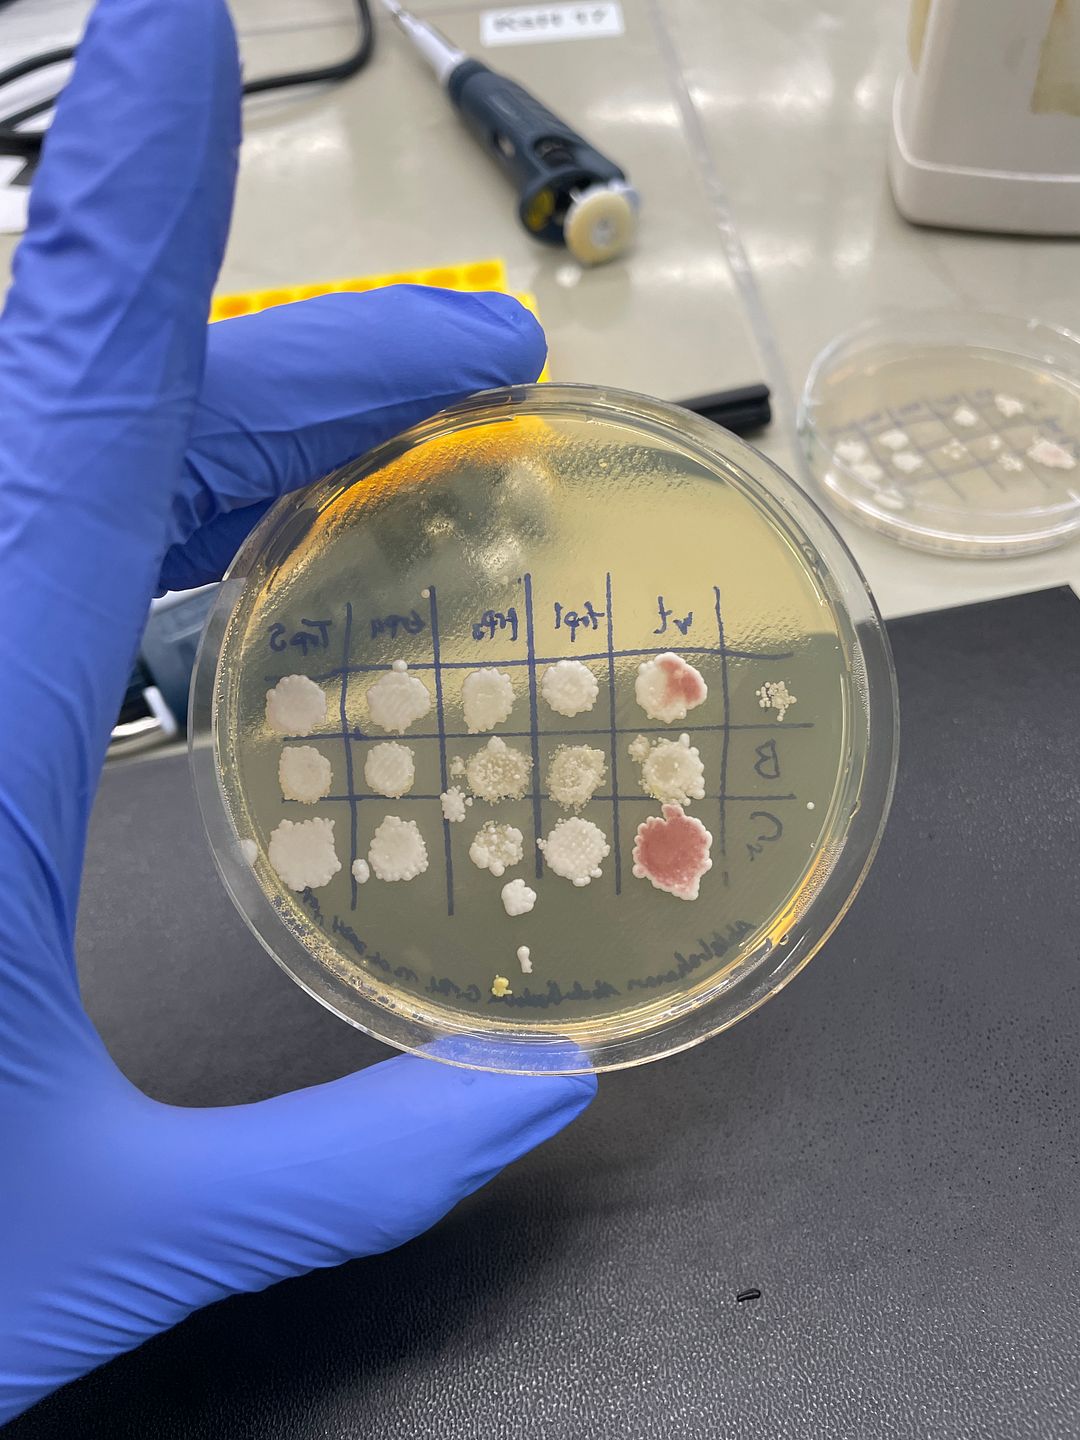

Bacterial cross mutation by ⏷
- Copy link to this page
- View on Zora
- View on Basescan
- Refresh edition metadata
IMAGE
4032x3024 3.2MB
Apr 21
0xffc8
Cross mutated and cloned E.coli with the wild type to creat a more resilient version that emits a red color and is immune against antibiotics.
Read more
📶 1 comment
Apr 21
kimballll
Interesting
✧
See all comments